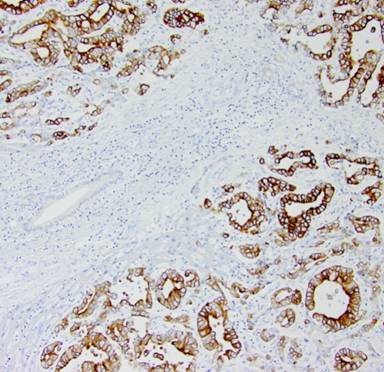

CASE REPORT
JOP. J Pancreas (Online) 2014 Sep 28; 15(5):515-519.
Metastatic Papillary Gallbladder Carcinoma with a Unique Presentation and Clinical Course
Brandon C Chapman1, Teresa Jones1, Martine C McManus2, Raj Shah2, Csaba Gajdos1
Departments of 1Surgery and 2Pathology, University of Colorado at Denver. Denver, CO, USA
ABSTRACT
Context Papillary gallbladder adenocarcinoma (PGA) represents 5% of malignant gallbladder tumors. Metastatic disease frequently involves lymph nodes or other structures in the hepatoduodenal ligament. Case report A Fifty-nine-year-old female with right upper quadrant pain and a giant gallbladder on ultrasound was found to have a segment 6 liver lesion during an attempted laparoscopic cholecystectomy. After appropriate staging, she underwent an open cholecystectomy and extended right hepatic lobectomy with portal lymph node dissection. Pathology demonstrated well-to-moderately differentiated PGA with identical morphology and immunohistochemistry in the liver resection specimen with negative margins. Despite adjuvant chemotherapy, she developed increased uptake in the head of the pancreas on PET scan. Endoscopic ultrasound with fine needle aspiration demonstrated metastatic PGA. She underwent an attempted Whipple operation but due to repeatedly positive pancreatic duct margins, she ended up with a total pancreatectomy and splenectomy. Final pathology showed metastatic PGA along the entire length of the pancreatic duct with only a single focus of tumor invasion into the pancreatic parenchyma. She developed a new liver metastases six months later that was unresponsive to FOLFOX therapy and she died of metastatic disease 33 months from her initial diagnosis. Conclusion To our knowledge, this is the first report of metastatic PGA recurring along the entire pancreatic duct with disease confined to the pancreas only. We hypothesize that papillary tumor cells spread to pancreatic duct via the common bile duct and remained dormant for several years. An aggressive surgical approach may prolong survival in well-selected patients with PGA’s.
INTRODUCTION
Gallbladder cancer is the 5th most common gastrointestinal malignancy and the most common malignant tumor of the biliary tract [1]. Gallbladder adenocarcinomas have historically been classified into gland forming (not otherwise specified), papillary, intestinal, pleomorphic giant cell, signet ring cells, mucinous, and clear cell types. In general, patients with gallbladder cancer have a poor prognosis. However, papillary gallbladder adenocarcinomas may have a better outcome compared with other types of carcinomas of the extrahepatic bile ducts due to the exophytic nature of the tumors, their late invasion into the duct wall [2], and early stage upon presentation[3]. We present a patient with metastatic papillary gallbladder adenocarcinoma to the liver and pancreatic duct.
CASE REPORT
A Fifty nine-year-old otherwise healthy Caucasian female presented to an outside hospital in November 2010 with right upper quadrant pain and an enlarged gallbladder on ultrasound. She was taken to the operating room where the planned laparoscopic cholecystectomy was aborted given the identification of a segment 6 liver lesions. Biopsy demonstrated metastatic adenocarcinoma with a suspected gallbladder primary. Computerized tomography (CT) scan showed a giant gallbladder measuring about 18 cm (Figure 1). A large mass (11.0x3.1 cm) was visualized within the gallbladder with no clear evidence of invasion into liver, cystic duct or proximal common bile duct. Two hypodense, right lobe liver lesions were also present with the dominant mass measuring 2.5x1.8 cm in segment 6 (Figure 2). Preoperative tumor markers including cancer antigen 19-9 (CA 19-9) and carcinoembryonic antigen (CEA) were normal.

|
Figure 1. Preoperative CT scan demonstrating giant gallbladder. |

|
Figure 2. Preoperative CT scan demonstrating metastatic segment 6 liver lesion. |
Secondary to her disease being potentially resectable, a diagnostic laparoscopy was performed to rule out extrahepatic disease. Biopsy of the segment 6 liver lesion demonstrated infiltrating glands staining diffusely for CK7, CK19, and CK20 consistent with a gallbladder primary (Figures 3 and 4). Concern was raised about the size of the left hemi-liver and the patient underwent portal vein embolization.

|
Figure 3. Histology of original gallbladder primary demonstrating well-to-moderately differentiated papillary gallbladder adenocarcinoma with invasion into lamina propria. |

|
Figure 4. Original gallbladder primary with positive CK20 staining. |
Following a restaging CT one month later, a cholecystectomy and extended right hepatic lobectomy with portal lymph node dissection were performed. The first cystic duct margin was positive for evidence of carcinoma. As the second intraoperative margin was negative and there was evidence of intrahepatic disease, we decided not to resect the common bile duct. Her 8-day postoperative course was complicated by a leak from the hepatic duct confluence, which was managed endoscopically with a sphincterotomy and stent placement.
The pathology specimen demonstrated a 10.0x6.5x0.5 cm papillary, pink, circumferential tumor located primarily in the body and neck of the gallbladder. Additional papillary areas that were non-contiguous with the main tumor were also identified in the body and fundus. The final cystic duct and liver margins were negative for any evidence of malignancy. Adenocarcinoma present in the liver resection specimen was morphologically identical to the gallbladder primary tumor (Figures 5 and 6). There was evidence of lympho-vascular invasion; however, no lymph nodes were identified in the sizable portal node dissection specimen. The patient underwent adjuvant chemotherapy with cisplatin and gemcitabine for six months and was followed by her local medical oncologist with tumor markers and serial imaging. Two years after her initial diagnosis, PET-CT showed a new 25x17 mm hypodense mass in the pancreatic head involving the main pancreatic duct causing mild upstream duct dilation and pancreatic parenchymal atrophy (Figure 7). There was no evidence of vascular invasion or biliary dilation on CT imaging. Endoscopic ultrasound showed a round hypoechoic mass in the inferior aspect of the pancreatic head and uncinate process measuring 23x21 mm in maximal cross section diameter. A fine needle aspirate (FNA) of the pancreas head mass demonstrated metastatic gallbladder carcinoma consistent with patient’s gallbladder primary.

|
Figure 5. Histology of metastatic papillary adenocarcinoma to the liver identical to gallbladder primary. |
|
Figure 6. Metastatic papillary gallbladder adenocarcinoma with positive CK20 staining. |

|
Figure 7. Metastatic papillary gallbladder adenocarcinoma in the uncinate process of the pancreas. |
Following a lengthy discussion in tumor board, the patient was taken to the operating room for an attempted Whipple operation. The first specimen had a positive pancreatic duct margin. Two additional positive margins were taken before the family elected to proceed with a total pancreatectomy and splenectomy. The patient had an uneventful 8-day postoperative course.
Final pathology showed diffuse PGA, morphologically and immune histochemically identical to the gallbladder primary. The entire length of the pancreatic duct was involved with intraductal exophytic papillary tumor with only a single focus of tumor invasion into the pancreatic parenchyma (Figure 8). All peripancreatic lymph nodes (0 of 10) were negative for malignancy. Gemcitabine and cisplatin were initiated again postoperatively. Patient was noted to have a new liver metastasis six month later. Systemic chemotherapy was switched to FOLFOX, but the disease continued to progress. The patient died of metastatic disease nine months after her total pancreatectomy (three years after her initial diagnosis).

|
Figure 8. Papillary adenocarcinoma growing along the pancreatic duct with identical histology to original gallbladder primary. |
DISCUSSION
The neoplasms of the biliary tree include the carcinomas of the intra- and extrahepatic bile ducts, the gallbladder and the ampulla. Recent evidence suggests that invasive biliary adenocarcinomas may be preceded by two types of precancerous lesions: the flat and non-tumor forming type that is called biliary intraepithelial neoplasia, and the papillary and tumor-forming type that has been named intraductal papillary neoplasm of the bile duct. The most recent WHO classification defines precancerous lesions of the biliary duct system, including the gallbladder and the ampulla, that are similar, if not identical, to the lesions that precede the invasive ductal adenocarcinoma and the mucinous (‘colloid’) carcinoma of the pancreas. The unifying term ‘intra(chole)cystic papillary-tubular neoplasms (ICPNs)’ has been proposed for all mass forming precursor lesions of the gallbladder. ICPNs present as exophytic, well-demarcated mass-forming tumors that measure >1 cm, are mostly solitary, and usually show mixture of papillary and tubular areas [4]. Only 6.4% of invasive carcinomas arise from a tumoral intraepithelial neoplasm; thus unlike the tubular GI tract, the adenoma-carcinoma sequence is responsible for only a small percentage of invasive carcinomas in the ampulla-pancreatobiliary tract, and the vast majority of invasive carcinomas in this system arise from flat (nontumoral) forms of intraepithelial neoplasia [5]. The prognostic relevance of histological subtypes of tubule-papillary precursors has yet to be determined and systematic characterization of the adenoma-carcinoma sequence of biliary precursors is needed to identify relevant biomarkers for patient stratification and risk assessment [4].
Papillary gallbladder adenocarcinoma (PGA) is a distinct clinical entity that represents about 5% of all malignant gallbladder tumors [6]. Patients typically present with symptoms similar to cholelithiasis, which may be secondary to the large papillary growth that fills the gallbladder lumen [7]. Our patient presented with classic symptoms of right upper quadrant pain and was found to have metastatic gallbladder cancer to the liver on planned laparoscopic cholecystectomy. This has been reported to occur in about one percent of patients after laparoscopic cholecystectomy for presumed biliary disease [8, 9].
Preoperative staging of gallbladder carcinoma is limited despite the advances of modern imaging techniques as most patients are evaluated after incidental finding of gallbladder carcinoma in cholecystectomy specimens. FDG-PET has been useful in differentiating benign versus malignant in several tumor types; however, its role in the preoperative diagnosis and management of patients with suspected GBC has not been established. Koh et al. evaluated 16 patients with protuberant gallbladder lesions that were suspicious for malignancy based on clinical findings, tumor markers, computed tomography, and ultrasound. In these patients, preoperative FDG-PET was performed and demonstrated 2 false negatives (sensitivity 75%, 6 of 8) and one false positive finding (specificity 87.5%, 7 of 8) in a patient with xanthogranulomatous cholecystitis (XGC). The authors proposed an algorithm that includes FDG-PET as an additional imaging modality and concluded that it may be useful in cases difficult to differentiate benign and malignant lesions of the gallbladder with conventional imaging modalities [10]. However, cautious interpretation is required as benign disease of the gallbladder including chronic cholecystitis [11], gallbladder tuberculosis [12], XGC [10], and Mirrizi syndrome [13] have been associated with a positive FDG-PET. Our patient did not have aFDG-PET prior to cholecystectomy and extended right hepatic lobectomy and may not have influenced management; however, it may have provided significant data on disease evolution. Further study is needed to identify the preoperative use of FDG-PET in disease of the gallbladder.
Histologically, our patient was found to have a diffuse, well-to-moderately differentiated papillary adenocarcinoma with tumor invasion into lamina propria (T1a). In general, PGAs presents at an earlier stage with up to 64% of patients having localized disease [3]. Sporadic reports also show that noninvasive PGA has a markedly improved survival compared to its invasive counterpart. The 5-year survival rate for PGA can be as high as 41% compared to 8-10% for patients with other types of gallbladder cancer [3]. Albores-Saavedra et al. examined the clinical and morphologic features of 16 noninvasive papillary carcinomas of the gallbladder and compared their clinical behavior with that of invasive papillary carcinomas. Noninvasive criteria included the following: predominant (>80%) papillary architecture, lack of infiltration into the wall of the gallbladder, and tumor size greater than 1.0 cm. The 10-year relative survival rate for tumors confined to the wall of the gallbladder was 52% compared to a 10-year survival of less than 10% in patients with lymph node metastases. Moreover, invasive papillary carcinomas of the gallbladder had a significantly better prognosis than invasive non-papillary carcinomas, which has a 10-year survival of only 30% when confined to the gallbladder wall [6].
Interestingly, our patient developed recurrence involving the entire pancreatic duct 2 years after initial presentation followed by a second liver metastases 6 months later. Metastatic gallbladder carcinoma has been reported to occur by several routes of spread. Fahim et al. evaluated 151 cases of gallbladder carcinoma at the Mayo Clinic from 1909 through 1950 to determine the mode of metastasis. Metastatic spread occurred via the following routes: lymphatic, vascular, interperitoneal “seeding”, neural, intraductal, or direct extension [14].
More recently, the incidence and mode of spread of carcinoma of the gallbladder were also described by Shimizu et al. Between 1985 and 2002, 50 consecutive patients with gallbladder carcinoma extending into the subserosa or beyond underwent radical surgery including extrahepatic bile duct resection and serial sections were histologically reviewed. They described 4 routes of spread: type I, direct spread from the primary tumor; type II, continuous intramural spread along the cystic duct and the extrahepatic bile duct; type III, non-contiguous metastatic spread separate from the primary tumor; and type IV, permeation of cancer cells from metastatic lymph nodes to the tissues of the hepatoduodenal ligament. Forty percent of patients (20/50) exhibited more than one more of spread [15].
Our patient had evidence of both vascular invasion, (which may explain the liver metastases)and lymphatic invasion; however, no lymph nodes were identified in the portal node dissection specimen following her first surgery. In addition, our patient had evidence of intraductal spread into the cystic duct, evidenced by the first surgical margin being positive on frozen section. In this form of spread, the tumor disseminates within the lumen of the ducts along the walls. It is plausible that our patient had Type II spread occult disease in her biliary and pancreatic ducts on initial presentation that progressed to macroscopic disease two years later.
Some surgeons advocate more extensive operations including resection of the extrahepatic bile ducts for locally advanced cancer of the gallbladder even in the absence of clinically apparent obstructive jaundice. They argue this procedure can facilitate complete clearance of the interstitial tissues of the hepatoduodenal ligament, which may contain occult metastatic disease and is important for an R-0 resection. As described above, Shimizu et al. evaluated the outcome of patients undergoing resection of the extrahepatic bile ducts irrespective of the existence of macroscopic cancer invasion and determined the incidence and mode of carcinoma extension along the extrahepatic bile duct. Invasion of the hepatoduodenal ligament was present in 24 of 44 patients without preoperative obstructive jaundice and in 2 of 13 patients with stage IB disease indicating that extrahepatic bile duct resection may be of value in patients with advanced gallbladder carcinoma even without apparent involvement of the hepatoduodenal ligament, since preservation of the extrahepatic bile duct may result in incomplete clearance of cancer cells [15]. Our patient may have benefited from an extrahepatic bile resection at the time of her initial cholecystectomy and extended right extended right hepatic lobectomy; however, it is difficult to predict improvement in outcome because gallbladder carcinoma has various modes of spread outside the confines of the gallbladder.
To our knowledge, this is the first report of resected invasive/metastatic PGA recurring in the entire pancreatic duct and with disease confined only to the pancreas. We hypothesize that papillary tumor cells spread to pancreatic duct via the common bile duct around the time or after initial surgery, but cancer cells remained dormant for nearly two years. This theory is further supported by finding no evidence of peritoneal disease or metastatic lymph nodes during subsequent pancreatectomy. Based on our experience, aggressive surgical approach may prolong survival in well-selected patients with advanced PGA’s.
Received May 10th, 2014 – Accepted September 2nd, 2014
Key words Adenocarcinoma, Papillary; Carcinoma; Cholecystectomy; Neoplasm Metastasis
Conflict of Interest The authors declare that they have no conflict of interest.
Correspondence
CsabaGajdos
Department of Surgery
University of Colorado at Denver
Mail
Stop C313
12631
East 17th Avenue, Room 6001
Aurora,
CO 80045
USA
Phone:
+1-303.724.2728
Fax: +1-303.724.2733
E-mail: csaba.gajdos@ucdenver.edu
References
1. Grobmeyer SR, Lieberman MD, Daly JM. Gallbladder cancer in the twentieth century: single institution’s experience. World J Surg. 2004; 28:47-49. [PMID:14639492]
2. Henson DE, Albores-Saavedra J, Corle D. Carcinoma of the gallbladder. Histologic types, stage of disease, grade, and survival rates. Cancer. 1992; 70: 1493-1497. [PMID:1516000]
3. Carriaga MT, Henson DE. Liver, gallbladder, extrahepatic bile ducts, and pancreas. Cancer. 1995; 75:171-190. [PMID:8000995]
4. Kloppel G, Adsay V, Konukiewitz B, Kleeff J, Schlitter AM, Esposito I. Precancerous lesions of the biliary tree. Best Pract Res Clin Gastroenterol. 2013; 27: 285-297. [PMID:23809246]
5. Adsay V, Jang K, Roac JC, Dursun N, Ohike N, Bagci P, et al. Intracholecystic Papillary-Tubular Neoplasms (ICPN) of the Gallbladder (Neoplastic Polyps, Adenomas, and Papillary neoplasms that are >1.0 cm): Clinicopathology and Immunohistochemical Analysis of 123 Cases. Am J Surg Pathol. 2012; 9:1279-1301. [PMID:22895264]
6. Albores-Saavedra J, Tuck M, McLaren BK, Carrick KS, Hensen DE. Papillary carcinomas of the gallbladder: analysis of noninvasive and invasive types. Arch Pathol Lab Med. 2005; 129: 905-909. [PMID:15974814]
7. Kim MJ, Kim KW, Kim HC, Kim SY, Park SH, Kim AY, et al. Unusual malignant tumors of the gallbladder. AJR Am J Roentgenol. 2006; 187:473-480. [PMID:16861553]
8. Choi SB, Han HJ, Kim CY, Kim WB, Song TJ, Suh SO, et al. Incidental gallbladder cancer diagnosed following laparoscopic cholecystectomy. World J Surg. 2009; 33:2657-2663. [PMID:19823903]
9. Ferrarese AG, Solej M, Enrico S, Falcone A, Catalano S, Pozzi G, et al. Diagnosis of incidental gallbladder cancer after laparoscopic cholecystectomy: our experience. BMC Surg 2013; 13:S20.
10. Koh T, Taniguchi H, Yamaguchi A, Kunishima S, Yamagishi H. Differential diagnosis of gallbladder cancer using positron emission tomography with fluorine-18-labeled fluorodeoxyglucose (FDG-PET). J Surg Oncol. 2003; 84:74-81. [PMID:14502780]
11. Oe A, Kawabe J, Torii K, Kawamura E, Higashiyama S, Kotani J, et al. Distinguishing benign from malignant gallbladder wall thickening using FDG-PET. Ann Nucl Med. 2006; 20: 699–703. [PMID:17385310]
12. Ramia JM, Muffak K, Fernández A, Villar J, Garrote D, Ferron JA. Gallbladder tuberculosis: false-positive PET diagnosis of gallbladder cancer. World J Gastroenterol. 2006; 12: 6559–60. [PMID:17072992]
13. Petrowsky H, Wildbrett P, Husarik DB, Hany TF, Tam S, Jochum W, et al. Impact of integrated positron emission tomography and computed tomography on staging and management of gallbladder cancer and cholangiocarcinoma. J Hepatol. 2006; 45: 43–50. [PMID:16690156]
14. Fahim RB, McDonald JR, Richards JC, Ferris DO. Carcinoma of the gallbladder: a study of its modes of spread. Ann Surg. 1962; 156: 114-124. [PMID:13891308]
15. Shimizu Y, Ohtsuka M, Ito H, Kimura F, Shimizu H, Togawa A, et al. Should the extrahepatic bile duct be resected for locally advanced gallbladder cancer? Surgery. 2004; 136:1012-1017. [PMID:15523394]